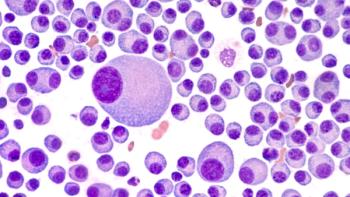

Keytruda Plus Lenvima Did Not Meet Primary Endpoints for First-Line uHCC Treatment
The median overall survival of the lenvatinib monotherapy arm is longer than that observed in previous clinical trials evaluating it as a monotherapy for unresectable hepatocellular carcinoma.
Merck and Eisai Inc announced that the phase 3 LEAP-002 trial, which investigated pembrolizumab (Keytruda; Merck) plus lenvatinib (Lenvima; Eisai) compared with lenvatinib as a monotherapy, did not meet its primary endpoints of overall survival (OS) and progression-free survival (PFS) as a first-line treatment for individuals with
“Our joint clinical development program for [pembrolizumab] plus [lenvatinib] is designed to address unmet needs for some of the most challenging-to-treat types of cancer, like [uHCC],” said Gregory Lubiniecki, MD, vice president of Global Clinical Development at Merck Research Laboratories, said in a statement. “We remain confident in the potential of this combination based on the body of evidence we’ve seen to date and will continue to investigate its role across multiple types of cancer.”
However, there were trends toward improvement in OS and PFS for individuals who received the combination compared with lenvatinib, but it was not statistically significant per the pre-specified statistical plan.
The median OS of the lenvatinib monotherapy arm in the study was longer than that observed in previous clinical trials evaluating it as a monotherapy in uHCC.
Additionally, the safety profile of pembrolizumab plus lenvatinib was consistent with previously reported data on the combination.
“Aiming for further improvement in the treatment of patients with [u]HCC, we selected [lenvatinib] monotherapy, a standard of care option, as the control arm of the LEAP-002 trial,” Corina Dutcus, MD, senior vice president of clinical research in oncology at Eisai, said in the statement. “While results evaluating the combination are not what we had hoped for, we will continue to contribute to the care of patients with [u]HCC by applying valuable knowledge from the LEAP-002 trial.”
Lenvatinib as a monotherapy is approved for the first-line treatment of individuals with uHCC in the China, Europe, and the United States. It is also approved for individuals with uHCC in Japan.
In the United States, pembrolizumab plus lenvatinib is approved for the treatment of individuals with advanced endometrial carcinoma that is not microsatellite instability-high or mismatched repair deficient, who have disease progression following prior systemic therapy in any setting and are not candidates for curative surgery or radiation. It is also approved for adults with advanced renal cell carcinoma in the first-line setting.
The combination is also approved in Europe and Japan. The results of the LEAP-002 trial do not affect the approved indications for the pembrolizumab plus lenvatinib combination.
The companies plan to present these data at an upcoming medical conference. They are also studying the pembrolizumab plus lenvatinib combination through the LEAP clinical program in more than 10 different tumor types, including biliary tract cancer, colorectal cancer, endometrial carcinoma, esophageal cancer, gastric cancer, glioblastoma, head and neck cancer, hepatocellular carcinoma, melanoma, non–small cell lung cancer, pancreatic cancer, and renal cell carcinoma across more than 15 clinical trials.
Reference
Merck and Eisai provide update on phase 3 LEAP-002 trial evaluating Keytruda (pembrolizumab) plus Lenvima (lenvatinib) versus Lenvima monotherapy in patients with unresectable hepatocellular carcinoma. News release. Merck. August 3, 2022. Accessed August 3, 2022. https://www.merck.com/news/merck-and-eisai-provide-update-on-phase-3-leap-002-trial-evaluating-keytruda-pembrolizumab-plus-lenvima-lenvatinib-versus-lenvima-monotherapy-in-patients-with-unresectable-hepatocellul/
Newsletter
Stay informed on drug updates, treatment guidelines, and pharmacy practice trends—subscribe to Pharmacy Times for weekly clinical insights.

















































































































































































































